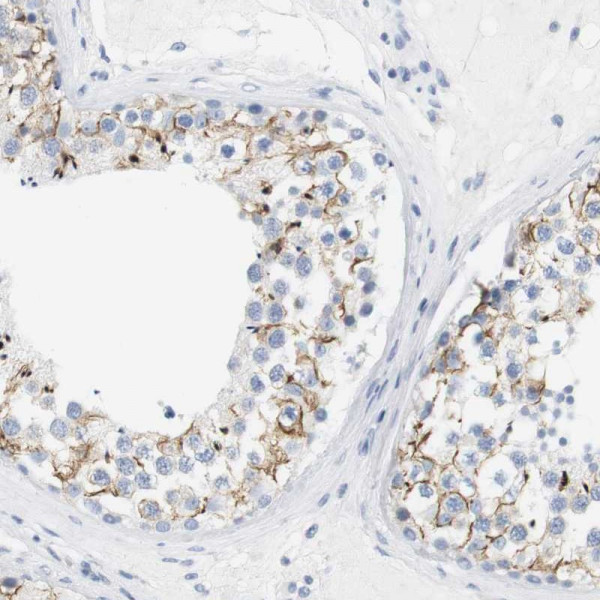
Anti-OPRM1

Cookie preferences
This website uses cookies, which are necessary for the technical operation of the website and are always set. Other cookies, which increase the comfort when using this website, are used for direct advertising or to facilitate interaction with other websites and social networks, are only set with your consent.
Configuration
Technically required
These cookies are necessary for the basic functions of the shop.
"Allow all cookies" cookie
"Decline all cookies" cookie
CSRF token
Cookie preferences
Currency change
Customer-specific caching
FACT-Finder tracking
Individual prices
Selected shop
Session
Comfort functions
These cookies are used to make the shopping experience even more appealing, for example for the recognition of the visitor.
Note
Show the facebook fanpage in the right blod sidebar
Statistics & Tracking
Affiliate program
Conversion and usertracking via Google Tag Manager
Track device being used
| Item number | Size | Datasheet | Manual | SDS | Delivery time | Quantity | Price |
|---|---|---|---|---|---|---|---|
| ATA-HPA014509.25 | 25 µl | - |
7 - 10 business days* |
330.00€
|
|||
| ATA-HPA014509.100 | 100 µl | - |
7 - 10 business days* |
463.00€
|
If you have any questions, please use our Contact Form.
You can also order by e-mail: info@biomol.com
Larger quantity required? Request bulk
You can also order by e-mail: info@biomol.com
Larger quantity required? Request bulk
Protein function: Receptor for endogenous opioids such as beta-endorphin and endomorphin.... more
Product information "Anti-OPRM1"
Protein function: Receptor for endogenous opioids such as beta-endorphin and endomorphin. Receptor for natural and synthetic opioids including morphine, heroin, DAMGO, fentanyl, etorphine, buprenorphin and methadone (PubMed:7905839, PubMed:7957926, PubMed:7891175, PubMed:12589820, PubMed:9689128). Agonist binding to the receptor induces coupling to an inactive GDP-bound heterotrimeric G-protein complex and subsequent exchange of GDP for GTP in the G-protein alpha subunit leading to dissociation of the G-protein complex with the free GTP-bound G-protein alpha and the G-protein beta-gamma dimer activating downstream cellular effectors (PubMed:7905839). The agonist- and cell type-specific activity is predominantly coupled to pertussis toxin- sensitive G(i) and G(o) G alpha proteins, GNAI1, GNAI2, GNAI3 and GNAO1 isoforms Alpha-1 and Alpha-2, and to a lesser extent to pertussis toxin-insensitive G alpha proteins GNAZ and GNA15 (PubMed:12068084). They mediate an array of downstream cellular responses, including inhibition of adenylate cyclase activity and both N-type and L-type calcium channels, activation of inward rectifying potassium channels, mitogen-activated protein kinase (MAPK), phospholipase C (PLC), phosphoinositide/protein kinase (PKC), phosphoinositide 3-kinase (PI3K) and regulation of NF-kappa-B. Also couples to adenylate cyclase stimulatory G alpha proteins. The selective temporal coupling to G- proteins and subsequent signaling can be regulated by RGSZ proteins, such as RGS9, RGS17 and RGS4. Phosphorylation by members of the GPRK subfamily of Ser/Thr protein kinases and association with beta- arrestins is involved in short-term receptor desensitization. Beta- arrestins associate with the GPRK-phosphorylated receptor and uncouple it from the G-protein thus terminating signal transduction. The phosphorylated receptor is internalized through endocytosis via clathrin-coated pits which involves beta-arrestins. The activation of the ERK pathway occurs either in a G-protein-dependent or a beta- arrestin-dependent manner and is regulated by agonist-specific receptor phosphorylation. Acts as a class A G-protein coupled receptor (GPCR) which dissociates from beta-arrestin at or near the plasma membrane and undergoes rapid recycling. Receptor down-regulation pathways are varying with the agonist and occur dependent or independent of G- protein coupling. Endogenous ligands induce rapid desensitization, endocytosis and recycling whereas morphine induces only low desensitization and endocytosis. Heterooligomerization with other GPCRs can modulate agonist binding, signaling and trafficking properties. Involved in neurogenesis. Isoform 12 couples to GNAS and is proposed to be involved in excitatory effects (PubMed:20525224). Isoform 16 and isoform 17 do not bind agonists but may act through oligomerization with binding-competent OPRM1 isoforms and reduce their ligand binding activity (PubMed:16580639). [The UniProt Consortium] Buffer: 40% glycerol and PBS (pH 7.2). 0.02% sodium azide is added as preservative. Highest antigen sequence identity to mouse: 41% and to rat: 40%
| Keywords: | Anti-MOP, Anti-hMOP, Anti-MOR1, Anti-OPRM1, Anti-MOR-1, Anti-M-OR-1, Anti-Mu opioid receptor, Anti-Mu opiate receptor, Anti-Mu-type opioid receptor |
| Supplier: | Atlas Antibodies |
| Supplier-Nr: | HPA014509 |
Properties
| Application: | IHC |
| Antibody Type: | Polyclonal |
| Conjugate: | No |
| Host: | Rabbit |
| Species reactivity: | human |
| Immunogen: | Recombinant Protein Epitope Signature Tag (PrEST) antigen sequence: LTLLSVSART GFCKKQQELW QRRKEAAEAL GTRKVSVLLA TSHSGARPAV STMDSSAAPT NASNCTDALA YSSCSPAPSP GSWVNLSHLD GNLSDPCGPN RTDLGGRDSL CPPTGSP (ATA-APrEST72740) |
Database Information
| KEGG ID : | K04215 | Matching products |
| UniProt ID : | P35372 | Matching products |
| Gene ID : | GeneID 4988 | Matching products |
| Protein Atlas Nr. : | ENSG00000112038 |
Handling & Safety
| Storage: | -20°C |
| Shipping: | +20°C (International: +20°C) |
Caution
Our products are for laboratory research use only: Not for administration to humans!
Our products are for laboratory research use only: Not for administration to humans!
Information about the product reference will follow.
more
You will get a certificate here
Viewed

